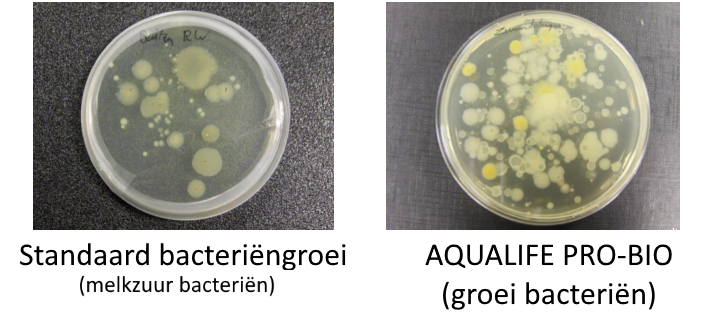
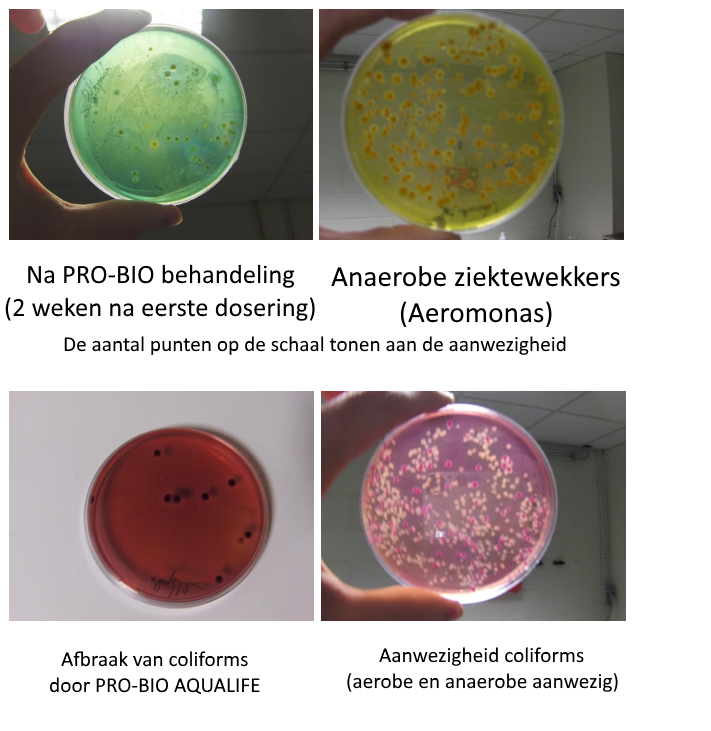

top of page


Het grootste aquariumbouw center van Europa!
AQUALIFE WEBSHOP
Meer informatie? + 32 11 64 79 86
✔ Snelle levering of ophalen in winkel
✔ Meer dan 3 000 artikelen uit voorraad leverbaar
✔ Verschillende online betaalmogelijkheden
✔ Deskundig en vrijblijvend advies
✔ Gratis levering vanaf € 85 (BE & NL)*
Zoek snel uw artikel!

AQUALIFE PRO-BIO BACTERIECULTUUR 1000 ML
SKU
50141
€17.50
Prijs incl.
BTW (21%) €3.04
Op voorraad
1
Bewaar dit product voor later
AQUALIFE PRO-BIO BACTERIECULTUUR 1000 ML
Productgegevens
AQUALIFE PRO-BIO BACTERIECULTUUR 1000 ML
Inhoud: 1000 ml
Dosering: wekelijks 150 ML / 1000 LITER inhoud, handmatig of met doseerpomp (zoetwater en zeewater aquaria).
Woordje over Aqualife PRO-BIO?
Een aquarium met "ups en downs" is nu echt verleden tijd. Bij Aqualife ervaren we het hobby houden op een hoger niveau, we maken bewust duurzame systemen waar de klant jarenlang plezier van heeft. Door de opkomende innovatieve markt zijn er afgelopen jaren ontzettend veel technieken en behandelingen op ons af gekomen, vele zaken waar we wat mee zijn en sommige die we misschien beter niet hadden aangekocht (lach)... door de hoge bomen zien we het bos zelfs niet meer.
Een aquarium houden is op één of andere manier een knap staaltje kunst. Het minimale watervolume waar we echt iets moois
natuurgetrouw van kunnen maken. We bootsen het natuurlijk habitat zo goed mogelijk na.
In de eerste zin verwijzen we naar "ups en downs". Dit was voorheen een gegeven bij elke aquarium hobbyist. Een natuurgetrouwe omgeving nabootsen met vissen is ook niet zo eenvoudig als het klinkt. Vaak gaat het goed met het aquarium maar zonder je het beseft keert het zich, we hebben niet direct zicht op het hele micro-gebeuren in het aquarium. Het bio systeem dat de verwerking doet van het
nitrificatie proces kan ons niet vertellen of ze onderbemand zijn om het aquarium zo zuiver mogelijk te houden.
Stabiliteit generen is het doel in elk aquarium! Een goede huisvesting bouwen voor goede bacteriën, denk dus aan een poreuze samenstelling van de stenen en filtermedium dat we in de filter plaatsen. Want wat doet bovenstaande eigenlijk met het aquarium? Een micro-organisme of microbe is een organisme dat te klein is om met het blote oog te zien. Alleen als ze met zeer veel zijn kunnen ze zichtbaar worden. De belangrijkste voorbeelden van micro-organismen zijn algen (draad alg, blauw alg,...), bacteriën en parasieten.
Bacteriën zijn het meest voorkomend en zijn ongeveer 1 micrometer groot, dat is een duizendste van een millimeter (1000 bacteriën op een rij is niet langer dan 1 millimeter)! Micro-organismen kunnen overal gevonden worden in de natuur. In grote aantallen komen ze overal voor: op de stenen, op het zand, in de filter,... De meerderheid van de micro-organismen is goedaardig, nuttig of zelfs noodzakelijk voor het aquariumsysteem. Er bestaan jammer genoeg ook een aantal micro-organismen die schadelijk of ‘vervelend’ zijn voor het aquarium. Ze kunnen bijvoorbeeld verantwoordelijk zijn voor ziektes, algen probleem of ophoping van anorganisch afval.
Waterwissels? Verleden tijd!
Hoewel ze de minderheid uitmaken bezorgen ze de micro organismen een heel slechte reputatie. Eender waar ze voorkomen (stenen, zand, water, vis, lager dier of plant) organiseren micro organismen zich tot een gemeenschap:
de microbiële gemeenschap of
microflora. Dergelijke gemeenschappen kunnen zeer divers en ook zeer complex zijn. "Elk soort micro organismen heeft zijn taak en draagt bij tot de gemeenschap". Samen hebben ze maar één doel: zo lang mogelijk met z’n allen overleven. Wanneer zo een microbiële gemeenschap of microflora zich op een vaste ondergrond bevindt (zand, hout, poreuze steen, filtermedium, noem maar op…) dan spreekt men van een
biofilm. Om in leven te blijven hebben microben net zoals ons voeding en drinken nodig (afval, uitwerpselen, plankton,...). Voeding vinden ze gemakkelijk onder het vele organische materiaal dat aanwezig is in water. Drinken doen microben door het absorberen van vocht, wat ze in watersystemen uiteraard overvloedig voorradig hebben. Het verwerken van voeding en vocht door microben noemt het
metabolisme.
Waarmee kunnen we u helpen?
Dankzij een nieuwe innovatieve ontwikkeling in goede bacteriën stellen we de AQUALIFE PRO-BIO voor. Een doeltreffend product dat in enkele dagen tijd ontzettende resultaten boekt in het aquarium.
Met dit product bent u verzekerd van een stabiel aquarium.
Met AQUALIFE PRO-BIO geleverd in vloeibare verpakkingen (1 liter of 5 liter) worden
Probiotische- (term die gebruikt wordt voor veilige, goede bacteriën die een gezondheidsbevorderend effect hebben op vissen en planten/koralen)
bacteriën in het water gebracht die onmiddellijk alle overbodige voedingsstoffen wegwerken
afbreken en verwijderen (nitraat, fosfaat, silicaten...), die anders ter beschikking staan voor parasieten, cyano's, algen en ziektes.
Wekelijkse waterwissels zullen dus minimaal of zelfs in meeste gevallen niet meer nodig zijn!
Aangezien onze bacteriën heel actief zijn, zullen ze het bio-systeem heel snel domineren en zorgen voor een gezonde en stabiele microflora. We raden een dosering aan van
100 ml / 1000 liter volume (zeewater of zoetwater biotoop) /
PER WEEK . Dit mag verspreid worden over de hele week (bv. aquarium volume 1000 liter, dagelijkse dosering 14 ml).
Te veel doseren kan geen kwaad (blijf hier redelijk in), dit gaat de populatie van goede bacteriën alleen maar versterken.
Ziektewekkers in de hobby
Iedereen heeft wel eens ooit één vis gehad met witte stip, schimmel of infecties... De vraag is vanwaar komen de parasieten en hoe ontstaan deze? Het ziekteproces begint eigenlijk allereerst bij de waterkwaliteit
Door Aqualife PRO-BIO zullen parasieten uit het water verwijderd worden. Hieronder een reeks onderzoeken van de meest voorkomende ziektewekkers in de zoet- en zeewater wereld. Deze Aeromonas en Coliforms zijn met Aqualife PRO-BIO binnen enkele weken volledig uit het water gefilterd.
BELANGRIJKE INFO!
Opgelet met andere koolstofbronnen bij zeewater aquaria (Biociden, azijnen,...) deze kunnen invloed hebben in combinatie met PRO-BIO.
Deze gelieve te verwijderen alvorens gebruik van PRO-BIO.
Nitraat en fosfaat nemen af door het toedienen van PRO- BIO consortium via indirecte stimulatie van de niet-heterotrofe micro-organismen. Wanneer de PIP bacteriën veel koolstofverbindingen afbreken, zullen de andere micro-organismen gestimuleerd worden om energie elders te vinden, zoals bij de stikstof en fosfaatverbindingen.
Hieronder een voorbeeld met rode flap dat slechts in 5 dagen volledig ontruimd wordt in het systeem door Aqualife PRO-BIO!


Toon prijzen
EUR
bottom of page